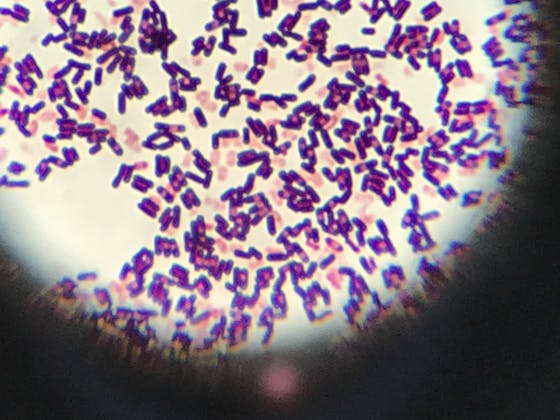

こんばんは
クラウドファンディングが伸び悩んでるので近況報告させていただきます。
最近、新たな実習が始まり、微生物の観察や分離、培養、遺伝子操作などを行っています。
上の画像はある微生物をグラム染色したときの画像です。気持ち悪い画像を載せてしまってすみません〓
これからの時期、蒸し暑くなってくると微生物で有名な大腸菌が食中毒を起こす季節になってきますね。
この画像のようにとても小さいですが数がとんでもなく多いので、人に悪さをしてしまいます。
食品の扱いや衛生環境には気をつけてくださいね。
もしよろしければ、クラウドファンディングの企画も読んでいただけると幸いです。
応援よろしくお願いします。







